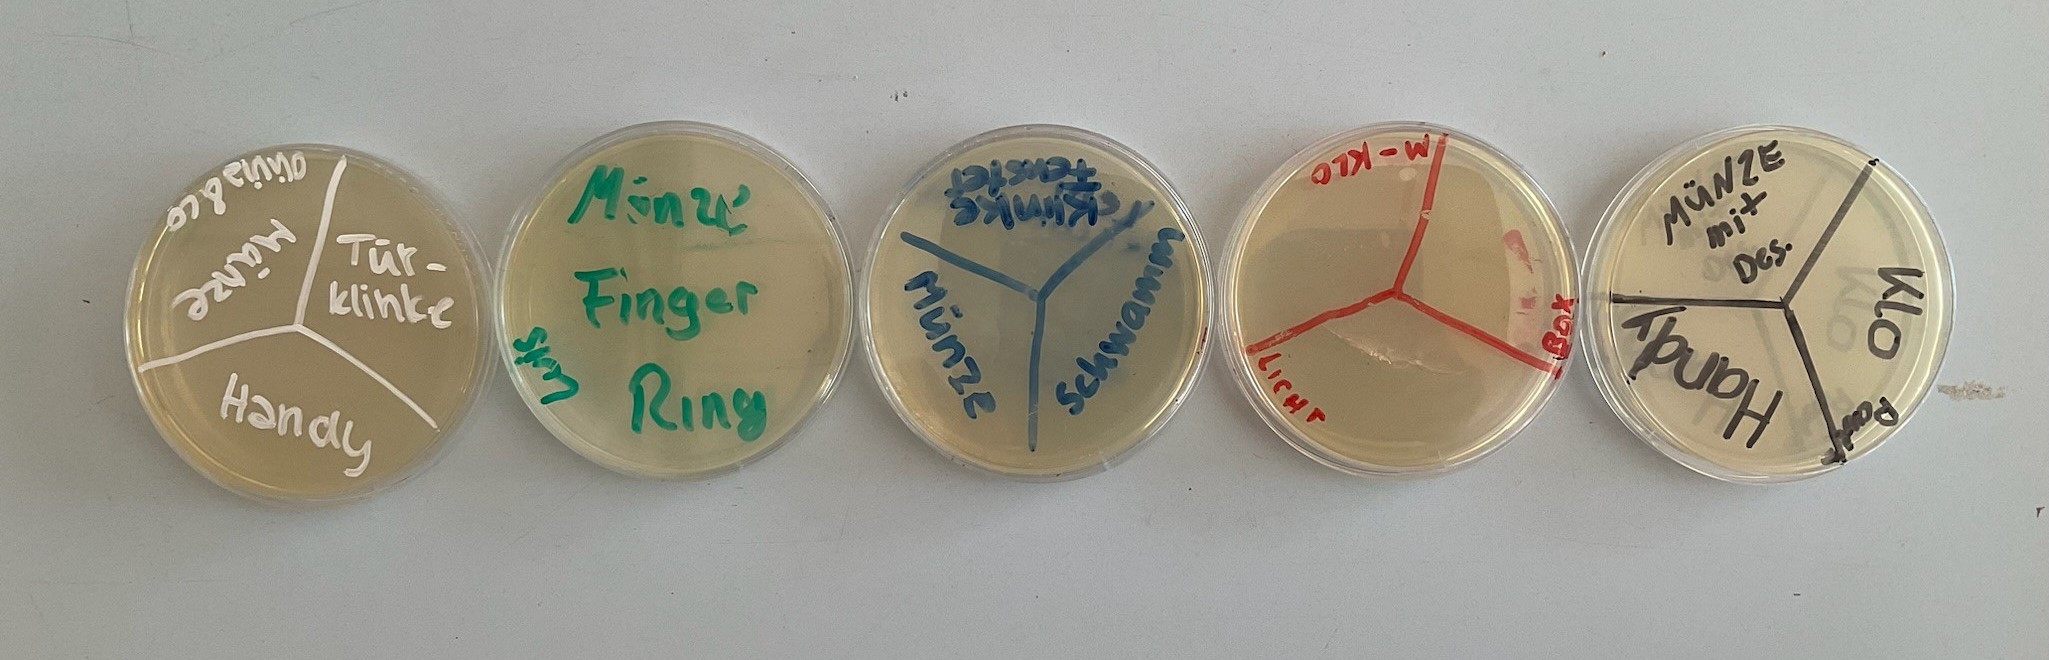
Bio10jhg1

Mittelstufe Biologie
In Klasse 8 beschäftigen sich die Schüler wieder eingehend mit dem Lebewesen Mensch. Schwerpunkte in diesem Jahrgang sind: Informationsverarbeitung, Fortpflanzung/ Individualentwicklung, Verhalten, Suchtgefahren und Gesundheit. Die Informationsaufnahme und –verarbeitung durch das Nervensystem (und Hormonsystem) wird in verschiedenen Selbstversuchen getestet. Zum Ende des Schuljahres stehen noch die Ökosysteme unter dem Einfluss des Menschen auf dem Programm.
Highlights: Sezieren eines Schweineauges, Projekt Be-Smart-Dont-Start, Projekt „Mit Sicherheit verliebt“, Polizeiprojekt „Sauba bleim“
Die 9. Jahrgangsstufe beschäftigt sich mit der Entwicklung des Lebens auf der Erde. Die einfachste Organisationsstufe von Lebewesen – die Bakterien – werden auf Agarplatten in Abklatschversuchen von Schülern gezüchtet, eukaryotische Zellen werden im Detail unter dem Mikroskop untersucht. Geübte Forscher finden im Heuaufguss schon mal verschiedene Kleinstlebewesen.
Ein weiterer Themenbereich dieser Jahrgangsstufe sind die wirbellosen Tiere – hier bietet sich die Durchführung verschiedener Projektarbeiten und das Üben neuer Präsentationstechniken an. Zudem werden die Grundlagen der Genetik und Gentechnik anschaulich vermittelt. Auch gewinnen die SchülerInnen Einblicke in die Evolution.
Highlights: Besuch von Ausstellungen im Museum Mensch und Natur

Hier sieht man die Erstellung eines Stop-Motion Videos zum Thema „Tranlation“ in der Genetik.
Und das fertige Meisterwerk:
Auch im Bereich Gentechnik bietet es sich an ein Stop-Motion-Video zu erstellen.
In Klasse 10 beschäftigen sich die Schüler mit dem Ökosystem Mensch, verschiedenen Krankheitserregern und wie sich der Körper gegen sie wehrt. Dieser Themenblock wird häufig projektorientiert unterrichtet und mit der Einübung von Präsentationstechniken verbunden. Anschließend steht weiterhin der Mensch mit seinen Organen im Mittelpunkt des Unterrichtsgeschehens. Am Ende des Jahrganges steht das Thema Vergangenheit und Zukunft des Menschen.
Abklatschversuche zu den Bakterien
SchülerInnen vollenden selbstständig Comics
Highlights: Lernen durch Lehren Projekt im 2. Halbjahr, Präparation Schweineherz, Vortrag zur Sporternährung und Nahrungsergänzungsmitteln
